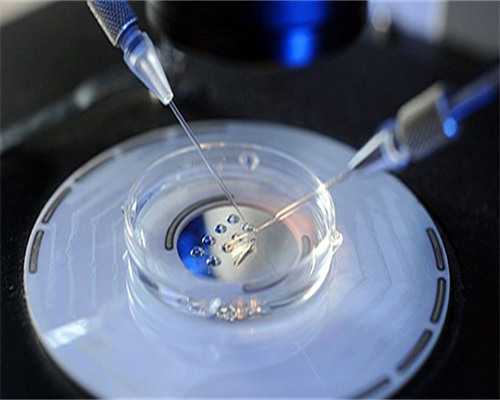
为什么做试管婴儿取不到卵子?

取卵作为试管婴儿中必不可少的环节,取卵对于试管婴儿的重要性不言而喻,真正做试管婴儿的家庭在之前都会经历促排卵的阶段,以此来保证同时获取更多的优质卵子,用来培育更多的优质胚胎,提高试管婴儿成功率.
但是,取卵也并不是越多越好,取卵太多的话会给卵巢造成负担,如果患者取卵太少的话,对后续的胚胎培养和移植都不利,那究竟是什么原因取卵太少或者取不到卵呢?
一、卵巢功能下降
一般来说,年龄越大,卵巢功能也相对较差,医生能取到的卵子也就也少.有很多不孕女性虽然年龄不大,但是因为长期的作息不规律或者饮食原因,导致卵巢早衰,如果促排的话,能得到1-2颗卵子就已经很不错了.
卵巢功能下降的最初表现就是月经周期不规律,如果每次月经都要提前几天,那么就应该去医院检查一下身体的激素水平,看看卵巢功能是否还正常.
还有,如果超过40岁,卵巢功能就会下降非常明显,试管婴儿的成功几率也会大幅下降,所以做试管婴儿要提早,如果等到卵巢功能即将衰竭才想起来做,即便试管婴儿也无力回天了.
二、取卵时间
试管婴儿取卵一般是在注射HCG之后的35-36小时之间取卵,夜针是促排卵结束、取卵之前打的最后一针,这一针一般会安排在晚上打,所以被称为夜针.
卵子是被卵丘细胞包围并粘附在卵泡壁上的,注射夜针的主要目的就是为了让卵泡加速成熟,使卵丘细胞结构变得松散,使卵子比较容易的从细胞壁脱落下来.
一般取卵时间和夜针时间不要小于35小时,因为此时卵泡还尚未成熟,而且卵丘细胞结构也还不松散,卵子不容易脱落,很可能导致取不到卵,或者破坏卵子结构.如果取卵时间超过36小时,那么很有可能一部分卵子已经脱落,自发排卵了,这样更加取不到卵子,以上两种情况都会导致取卵少,甚至取不到卵子.
取卵时间和医生的经验息息相关,每个人的情况不同,取卵时间也不太一样,即便是相同的用药和流程,最后的排卵时间也有可能不同,有的可能不到35小时就排卵了,而有些则是过了36小时还卵泡还没有成熟,这些体质差异都需要用医生的经验来弥补.
三、卵泡质量
试管婴儿促排时,医生会使用B超监测卵泡,但也只能看到卵泡外形,至于其中有没有卵子、卵子的质量好不好也只有取出来才会知道.
B超监测到的卵泡也不一定就有卵子,而且有些卵泡的形态不规则或者激素水平不好的患者很有可能存在空的卵泡,而且外形太大或者太小都有可能是没有卵子的.
四、取卵过程中的损失
试管婴儿取卵过程中是医生在仪器监测下将穿刺针穿过阴道吸取卵子的过程,虽然医生会高度集中,但过程中还是会有些损失,特别是有些人的卵泡张力太差,导致取卵针无法伸进卵泡当中吸取卵子,或者吸的时候卵泡壁塌陷太早,吸不出卵子.
此外,做试管婴儿会存在肥胖、卵巢位置高、呼吸困难等情况,这些情况都会让卵泡在B超下的成像不清晰,再有卵泡会随着呼吸而移动,这些过程都会导致在取卵过程中损失增加.
所以试管婴儿在备孕过程中要注意休息,不能熬夜,同时患者应该多锻炼,比如饭后散步等,坚持健康绿色的生活方式,防止卵巢早衰.
而那些正在走上或者准备做试管婴儿道路上的妈妈们,平时也要多保养身体,即便取出的卵子数量不多,大家也不要泄气,因为试管婴儿成功率除了与卵子数量相关外,还与卵子的质量有关,如果卵子品质高,其所能配出的胚胎质量也会更高.
Tips:
为什么做试管婴儿会取不到卵子?
在试管婴儿促排卵期间,医生会经常为患者做B超监测卵泡的生长情况,有的患者发现在促排卵时还能得知自己一共有多少个卵泡在生长,可是到了取卵的时候,医生告知并没有取到相应的卵子,为什么在促排监测排卵时都能够看到卵了,在取卵的时却并没有取到呢?
主要存在以下几个问题
01、年龄问题
一些年龄较大的女性,由于自身激素水平出现了下降,卵巢的储备功能降低,虽然在B超的检测下发现有卵泡的存在,但是在取卵时却没有卵子,只有空卵泡的存在,这就是所谓的空卵泡症状,年龄偏大卵巢功能衰退,是一种不可逆转的生理现象,所以在做试管婴儿时,年龄确实是试管成功路上一只巨大的拦路虎,因此,不管是自然怀孕还是试管婴儿治疗,一定要趁早进行。
02、卵巢疾病和创伤
卵巢在遭遇疾病侵袭后,卵巢功能受到破坏,导致功能衰退卵子储备受损,比如卵巢肿瘤等疾病进行手术后,造成部分生物组织被切除的物理损伤,在遇到疾病后的治疗,如化疗、放疗、免疫性疾病治疗等等,这些原因都会破坏卵巢的储备功能,造成取卵困难或许取不到卵子。
03、提前排卵及卵泡发育障碍
在试管婴儿促排时,有可能卵子出现提前成熟后就排出了,有时在促排期间夫妻有进行同房,促使卵子提前排出导致取卵时无卵可取,还有部分患者在促排卵时用药的方案不太理想,对药物不敏感出现卵泡长不大的情况,这就需要医生调整用药方案促进卵子成熟,当然,合适的条件下可以在实验室继续培养不成熟的卵子达到成熟的标准。
造成在试管周期中出现取不到卵子的因素有很多,这样的情况是每个人都不愿意看到的,如果没取到卵希望大家也不要太着急,选择更好的试管技术,调整好心态再重新开始新的取卵周期,哪怕就是完全没有卵子可取,在泰国,通过泰国试管婴儿技术和泰国合法辅助生殖治疗,都是可以实现生育孩子愿望的。
【代生的代价】
|
| 在哪能找到代怀的_代怀贵不贵_4n8rv_孕期,胎心胎芽迟迟没出现,是怎么回事? |
|
| 合肥供借卵价格 合肥做试管婴儿的医院 ‘45天看孕囊生男孩女孩的准确率有多 |
|
| 买精生子的喜悲:单身妈妈花50万称很幸福,有精神病人捐精26个家庭 |
|
| 那些吃来曲唑片促排成功怀孕双胞胎的案例多吗? |
|
| 哪家机构代怀_代怀孕的权威机构_黄石试管婴儿的具体操作流程 |
|
| 2026年去南通妇幼保健院做第一代试管婴儿要多少钱? |
